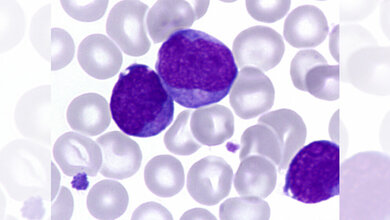
Blutausstrich_einer_Vorleukaemie_bei_einem_Kind_mit_Down_Syndrom_Jan_Henning_Klusmann.jpg Blutausstrich einer Vorleukämie

Ein Team der Klinik für Kinder- und Jugendmedizin I am Universitätsklinikum Schleswig-Holstein (UKSH), Campus Kiel, und der Medizinischen Fakultät der Christian-Albrechts-Universität zu Kiel (CAU) hat gemeinsam mit Partnerinstitutionen aus der dänischen Region Seeland das Interreg-Projekt „HomeHemo“ für eine verbesserte Versorgung von Krebspatientinnen und -patienten eingeworben: Gemeinsam wollen die Projektbeteiligten um den Kieler Kinderonkologen Prof. Denis Schewe und den Versorgungsforscher Dr. Dr. Fabian-S. Frielitz von der Universität Lübeck ein Bluttestverfahren zur Überwachung des Gesundheitszustands bei Blutkrebserkrankungen für die Anwendung zu Hause entwickeln.
Die Europäische Union fördert das Vorhaben im Rahmen eines Interreg-Netzwerkprojekts für zunächst zwölf Monate mit rund 120.000 Euro. In dieser Zeit wollen die beteiligten Institutionen zunächst eine Machbarkeitsstudie durchführen, in der bestehende Bluttestgeräte auf ihre Eignung für die Selbsttestung in häuslicher Umgebung bei Kindern und Erwachsenen überprüft werden sollen. Ziel des Gesundheitsinnovationsprojektes ist es, belastende Krankenhausaufenthalte speziell bei Leukämiepatientinnen und -patienten zu reduzieren. Diese sind derzeit zur Überprüfung des Blutbildes während der Chemotherapie häufig und in kurzen zeitlichen Abständen notwendig. Neben der CAU und dem UKSH mit den Standorten Kiel und Lübeck ist auch das Universitätsklinikum der dänischen Region Seeland daran beteiligt, wo Dr. Mikkel Helleberg Dorff aus der Hämatologie im Krankenhaus Roskilde und Dr. Niels Henrik Holländer aus der Onkologie in Næstved für den dänischen Beitrag des „HomeHemo“-Projekts verantwortlich sind.
Unnötige Krankenhausaufenthalte vermeiden
Bei vielen Krebspatientinnen und -patienten ist eine häufige Überprüfung des Blutbildes notwendig, um den Verlauf der Krankheit sowie den Erfolg und die Nebenwirkungen von Therapien überprüfen zu können. Speziell bei Leukämieerkrankungen, bei denen die Chemotherapie eine gestörte Blutbildung verursacht, wird unter anderem die Zahl der weißen und roten Blutkörperchen sowie der Blutplättchen laufend überwacht. Ärztinnen und Ärzte können so beurteilen, wann bestimmte kritische Grenzwerte erreicht sind und eine Bluttransfusion nötig wird. Gerade bei Leukämien müssen diese Werte besonders engmaschig überwacht werden.
Im derzeitigen Behandlungsalltag bedeutet dies, dass Patientinnen und Patienten manchmal sogar in 24- bis 48-stündigen Abständen für ein Blutbild ins Krankenhaus kommen müssen. Sind sie nicht sowieso in stationärer Behandlung, ist dies für die Betroffenen mit großen Belastungen verbunden. „Manche unserer Patientinnen und Patienten sind mehrere Stunden mit dem Auto unterwegs, um in der Klinik einen ambulanten Bluttest zu machen, der selbst nur wenige Minuten beansprucht“, betont Projektleiter Schewe. „Neben den Fahrt- und Wartezeiten bedeuten die häufigen Krankenhausbesuche psychischen Stress, nicht nur für viele Patientinnen und Patienten, sondern auch für deren Familien, besonders wenn Kinder betroffen sind“, so Studienärztin Dr. Annika Rademacher aus der Kieler Kinderonkologie.
Anwendbarkeit für Patientinnen und Patienten optimieren
Das Projektteam sucht daher nach Wegen, um die Anzahl dieser belastenden Krankenhausaufenthalte zu reduzieren oder möglichst ganz zu ersetzen. Technisch gesehen ist die Durchführung von Bluttests außerhalb einer Praxis oder eines Krankenhauses unproblematisch. Es sind verschiedene Testgeräte zur Überprüfung diverser Blutparameter verfügbar, die sich grundsätzlich für die Nutzung durch medizinische Laien, also auch durch Patientinnen und Patienten oder deren Eltern, eignen.
Trotzdem gibt es verschiedene Hürden für eine Anwendung in häuslicher Umgebung. „Besonders schwierig kann das bei jungen Kindern sein“, sagt Schewe. „Hier ist dann zum Beispiel von den Eltern gefordert, Kinder zu beruhigen, ihnen die Angst zu nehmen und zugleich valide Testergebnisse zu gewinnen. Damit dies gelingt, muss die Durchführung solcher Selbsttests so einfach wie möglich gestaltet sein“, so Schewe weiter.
Pilotprojekt startet im Sommer
Um diesen Herausforderungen zu begegnen, wollen die Projektpartner aus Schleswig-Holstein und Dänemark bereits im Sommer mit einer Pilotphase beginnen. Eine Gruppe von Studienteilnehmerinnen und -teilnehmern soll dann in ärztlicher Begleitung die derzeit in Entwicklung befindlichen Testprozeduren erproben. Die ärztliche Überwachung dieser Projektphase dient unter anderem dazu, die Qualität der gewonnenen Daten zu kontrollieren. Ziel ist es, die Selbsttests so zu optimieren, dass ihre Ergebnisse mit den routinemäßigen Tests durch medizinisches Personal übereinstimmen. Hierzu werden die Messungen der Selbsttests mit den klinischen Kontrollmessungen verglichen. Zusätzlich werden die Probandinnen und Probanden von einem Evaluationsteam begleitet.
In qualitativen Befragungen können die Betroffenen ihre Erfahrungen schildern und beschreiben, wie sie mit der Durchführung zurechtkommen und welche Probleme für sie aufgetreten sind. „Neben den Aspekten von Validität und Reliabilität der Messungen ist es uns wichtig, die Benutzerfreundlichkeit zu analysieren. Schließlich muss die Technik nahezu selbsterklärend für die Patientinnen und Patienten sein. Wir hoffen, durch das neue Versorgungselement „HomeHemo“ die Belastungen, die durch häufige Krankenhausbesuche für Betroffene entstehen, reduzieren zu können“, sagt Versorgungsforscher Frielitz. Darauf aufbauend wollen die Projektverantwortlichen ein Schulungsangebot entwickeln, dass Patientinnen und Patienten und ihren Angehörigen die sichere und intuitive Anwendung der Tests vermitteln soll. Dass Krankenhauskapazitäten und Gesundheitsbudgets so künftig geschont werden könnten, ist ein erhoffter weiterer Effekt des Projekts.
Einbindung in die Telemedizin
Über die demnächst anlaufende Machbarkeitsstudie hinaus planen die Projektteams in Schleswig-Holstein und Seeland bereits den nächsten Schritt: Nach der Entwicklung des eigentlichen Testverfahrens wollen sie die Daten aus den Heimtests künftig in ein telemedizinisches System einbinden. „Die nächste Frage für uns ist: Wie kommen die Patientendaten zu den Ärztinnen und Ärzten?“, sagt Schewe. „Damit die Bluttests zu Hause Sinn machen, ist eine möglichst einfache Übertragung besonders wichtig. Wir planen mit verschiedenen Möglichkeiten, zum Beispiel der Bluetooth-Übertragung der Blutwerte an Mobilgeräte oder der sicheren Weiterleitung der Ergebnisse in eine elektronische Patientenakte via App“, so Schewe weiter.
Bei der Entwicklung der dafür nötigen IT-Infrastrukturen wollen die Partnerinstitutionen auf Erfahrungen aus Schleswig-Holstein und Seeland zurückgreifen. So ist zum Beispiel mit „KULT-SH: Telemedizin mit krebskranken Kindern“ bereits ein Projekt am UKSH in Kiel gestartet, das die Möglichkeiten der Digitalisierung zur Verbesserung der Versorgung von jungen Krebspatientinnen und -patienten erschließen soll. Um auch das „HomeHemo“-Projekt vollständig umzusetzen und in die bestehende Infrastruktur einzubinden, wollen die Projektpartner im kommenden Jahr umfangreiche Folgeförderungen bei der Europäischen Union beantragen und damit die grenzübergreifende Zusammenarbeit für eine verbesserte Krankenversorgung, Wissensaustausch und Innovation vorantreiben.
Quelle: CAU, 17.05.2021
Artikel teilen